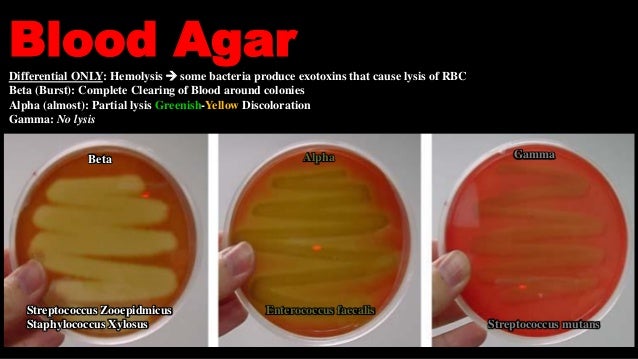

Streptococcus Mutans Msa Plate

Pdf Quantification Of Streptococcus Mutans In Different Types Of Ligature Wires And Elastomeric Chains

Gallery Of Bacteria Photo Gallery Of Bacterial Species Images Of Common Medically Important Bacteria
Http Faculty Sdmiramar Edu Dtrubovitz Micro Microhandouts Labs Staphstreptenteric Pdf

Effect Of Salivary Pellicle On Antibacterial Activity Of Novel Antibacterial Dental Adhesives Using A Dental Plaque Microcosm Biofilm Model Abstract Europe Pmc

Spontaneously Arising Streptococcus Mutans Variants With Reduced Susceptibility To Chlorhexidine Display Genetic Defects And Diminished Fitness Biorxiv
1
Ilovemicrobiology Ilana Kovach
Http Faculty Sdmiramar Edu Dtrubovitz Micro Microhandouts Labs Staphstreptenteric Pdf

Spontaneously Arising Streptococcus Mutans Variants With Reduced Susceptibility To Chlorhexidine Display Genetic Defects And Diminished Fitness Biorxiv

Week 10w New This Week Last Week Gram Bacteria Id Ppt Video Online Download

Methods Of Biotyping Of Streptococcus Mutans Species With The Routine Test As A Prognostic Value In Early Childhood Caries

Pdf Streptococcus Mutans And Cardiovascular Diseases

Selective And Differential Media Ppt Download

Pdf Evaluation Of Changes In Streptococcus Mutans Colonies In Microflora Of The Indian Population With Fixed Orthodontics Appliances

Biotechnological Applications Of Two Novel Lytic Bacteriophages Of Streptococcus Mutans In Tooth Decay Bio Controlling Scialert Responsive Version
Http Faculty Sdmiramar Edu Dtrubovitz Micro Microhandouts Labs Staphstreptenteric Pdf

Streptococcus Mitis An Overview Sciencedirect Topics

Spontaneously Arising Streptococcus Mutans Variants With Reduced Susceptibility To Chlorhexidine Display Genetic Defects And Diminished Fitness Biorxiv

Dental Plaque Microcosm Response To Bonding Agents Containing Quaternary Ammonium Methacrylates With Different Chain Lengths And Charge Densities Abstract Europe Pmc
Q Tbn 3aand9gctnx Wecq2e2d59exdiacpnnfhbzsbiv1pnvq5ncxdno8cfthsy Usqp Cau

Welcome To Microbugz Mannitol Salt Agar

Streptococci Overview Of Detection Identification Differentiation And Cultivation Techniques Sigma Aldrich

Streptococci Overview Of Detection Identification Differentiation And Cultivation Techniques Sigma Aldrich

Experiment 8c Lab Period 2
Http Faculty Collin Edu Mweis Microbiology Lab Micro lab manual Microbiology lab manual Rvsd Fall17 Pdf

Ilovemicrobiology Ilana Kovach
Edusj Mosuljournals Com Article 9ebbba75e330de Pdf

Solved Please Help With 5 6 And 7i Do Not Have Additiona Chegg Com

What Is The Basis Of Blood Agar For The Isolation Of Streptococcus Mutans From Dental Caries

Methods Of Biotyping Of Streptococcus Mutans Species With The Routine Test As A Prognostic Value In Early Childhood Caries

Bio265 Lab 6 1 Xbc And 1xcs Dr Di Bonaventura

Pdf Antimicrobial Effect Of Honey On Streptococcus Mutans Of Dental Plaque

Microbewiki Streptoccus Mutans And Dental Caries Microbewiki

Microbiology Lab Practical Flashcards Quizlet

N6zgcskp8osg2m
Bluegrass Kctcs Edu Education Training Media Natural Sciences Biology Documents Bio 225 Labmanual Pdf

Asmscience Mannitol Salt Agar Plates Protocols

How To Identify Streptococcus Species Using Selective Agars Youtube

Frontiers Evaluating Streptococcus Mutans Strain Dependent Characteristics In A Polymicrobial Biofilm Community Microbiology

Candida Albicans Promotes Tooth Decay By Inducing Oral Microbial Dysbiosis The Isme Journal

A Lacticin 3147 Enriched Food Ingredient Reduces Streptococcus Mutans Isolated From The Human Oral Cavity In Saliva O Connor 06 Journal Of Applied Microbiology Wiley Online Library

Pdf Isolation And Identification Of Streptococcus Mutans From Dental Caries By Using Sm479 Gene
Mountainscholar Org Bitstream Handle 500 4773 Lab Manual Unit 6 Pdf Sequence 9 Isallowed Y

Staph And Strep Ppt Download
Edusj Mosuljournals Com Article 9ebbba75e330de Pdf

Ijms Free Full Text Light Energy Dose And Photosensitizer Concentration Are Determinants Of Effective Photo Killing Against Caries Related Biofilms Html
Covr And Vicrk Regulate Cell Surface Biogenesis Genes Required For Biofilm Formation In Streptococcus Mutans

Streptococcus Salivarius Wikipedia

Spontaneously Arising Streptococcus Mutans Variants With Reduced Susceptibility To Chlorhexidine Display Genetic Defects And Diminished Fitness Biorxiv

Comparative Evaluation Of Various Probiotic Strains On Inhibition Of Streptococcus Mutans An In Vitro Study
Streptococcus Agalactiae Wikipedia

Mannitol Salt Agar For The Isolation Of Staphylococcus Aureus

Pdf Glucose Sucrose Potassium Tellurite Bacitracin Agar An Alternative To Mitis Salivarius Bacitracin Agar For Enumeration Of Streptococcus Mutans

Pdf Isolation And Identification Of Mutan S Streptococci Bacteria From Human Dental Plaque Samples

Oral Streptococcal Species Detected By Pcr From Dental Biofilm Samples Download Scientific Diagram

Mannitol Salt Agar Wikipedia

Solved 7 You Are Working In A Dentist Office When A Pati Chegg Com

Streptococcus Mutans Wikipedia
Asm Org Getattachment 7ec0de2b 16 4f6e Ba07 2aea25a43e76 Protocol 25 Pdf

Identification Of Gtfb Gfti Sequence Of Streptococci And Its Prevalence In Cariogenic Patients Presented At University College Hospital Of Medicine And Dentistry Lahore Pakistan During 16 17
Variable Characteristics Of Bacteriocin Producing Streptococcus Salivarius Strains Isolated From Malaysian Subjects

Probiotic Lactobacillus Sp Inhibit Growth Biofilm Formation And Gene Expression Of Caries Inducing Streptococcus Mutans Wasfi 18 Journal Of Cellular And Molecular Medicine Wiley Online Library
1

Pathogenic Bacteria And Identification Microbiology Learning The Why Ology Of Microbial Testing

Methods Of Biotyping Of Streptococcus Mutans Species With The Routine Test As A Prognostic Value In Early Childhood Caries

Spontaneously Arising Streptococcus Mutans Variants With Reduced Susceptibility To Chlorhexidine Display Genetic Defects And Diminished Fitness Antimicrobial Agents And Chemotherapy

Silver Nanoparticles With Antimicrobial Activities Against Streptococcus Mutans And Their Cytotoxic Effect Sciencedirect

Spontaneously Arising Streptococcus Mutans Variants With Reduced Susceptibility To Chlorhexidine Display Genetic Defects And Diminished Fitness Biorxiv
Q Tbn 3aand9gcs3nlev0tx1pfsddwm6y9ajujk4lxjzmg7ksdxctgnipv0l50c Usqp Cau

Msa Streptococcus Mutans Pdf Document

Frontiers The Role Of Candida Albicans Secreted Polysaccharides In Augmenting Streptococcus Mutans Adherence And Mixed Biofilm Formation In Vitro And In Vivo Studies Microbiology

Spontaneously Arising Streptococcus Mutans Variants With Reduced Susceptibility To Chlorhexidine Display Genetic Defects And Diminished Fitness Biorxiv

Staphylococcus Aureus Bacterial Pathogenesis

Frontiers The Role Of Candida Albicans Secreted Polysaccharides In Augmenting Streptococcus Mutans Adherence And Mixed Biofilm Formation In Vitro And In Vivo Studies Microbiology
Http Europepmc Org Articles Pmc Pdf Jcm 0115 Pdf

Role Of Streptococcus Mutans In Human Dental Decay

Biotechnological Applications Of Two Novel Lytic Bacteriophages Of Streptococcus Mutans In Tooth Decay Bio Controlling Scialert Responsive Version

Pdf Isolation And Identification Of Mutan S Streptococci Bacteria From Human Dental Plaque Samples
Edusj Mosuljournals Com Article 9ebbba75e330de Pdf

Mannitol Salt Agar Msa Plate
Www Jstor Org Stable

Frontiers Recombineering In Streptococcus Mutans Using Direct Repeat Mediated Cloning Independent Markerless Mutagenesis Dr Cimm Cellular And Infection Microbiology

Msa Streptococcus Mutans Streptococcus Microbiology

Probiotic Lactobacillus Sp Inhibit Growth Biofilm Formation And Gene Expression Of Caries Inducing Streptococcus Mutans Wasfi 18 Journal Of Cellular And Molecular Medicine Wiley Online Library

Methods Of Biotyping Of Streptococcus Mutans Species With The Routine Test As A Prognostic Value In Early Childhood Caries

Frontiers The Role Of Candida Albicans Secreted Polysaccharides In Augmenting Streptococcus Mutans Adherence And Mixed Biofilm Formation In Vitro And In Vivo Studies Microbiology

Methods Of Biotyping Of Streptococcus Mutans Species With The Routine Test As A Prognostic Value In Early Childhood Caries

Pathogenic Bacteria And Identification Microbiology Learning The Why Ology Of Microbial Testing

Assessment Of Dental Caries Experience Along With Streptococcus Mutans Streptococcus Sanguis And Candida Count Among Male Tobacco Users Visiting A Dental Institute Of Mangalore Karnataka India A Cross Sectional Study

Effect Of Salivary Pellicle On Antibacterial Activity Of Novel Antibacterial Dental Adhesives Using A Dental Plaque Microcosm Biofilm Model Abstract Europe Pmc

Ilovemicrobiology Ilana Kovach
Spontaneously Arising Streptococcus Mutans Variants With Reduced Susceptibility To Chlorhexidine Display Genetic Defects And Diminished Fitness Antimicrobial Agents And Chemotherapy

Microbewiki Streptoccus Mutans And Dental Caries Microbewiki
Edusj Mosuljournals Com Article 9ebbba75e330de Pdf
Www Jstor Org Stable

Pdf Recombineering In Streptococcus Mutans Using Direct Repeat Mediated Cloning Independent Markerless Mutagenesis Dr Cimm

Staphylococcus Aureus And Staphylococcus Epidermidis On Mannitol Salt Agar Mannitol Salt Agar Composition Positive And Negative Result On Mannitol Salt Agar

Msa Streptococcus Mutans Pdf Document

Spontaneously Arising Streptococcus Mutans Variants With Reduced Susceptibility To Chlorhexidine Display Genetic Defects And Diminished Fitness Antimicrobial Agents And Chemotherapy

Effects Of Dual Antibacterial Agents Mdpb And Nano Silver In Primer On Microcosm Biofilm Cytotoxicity And Dentine Bond Properties Abstract Europe Pmc

Biotechnological Applications Of Two Novel Lytic Bacteriophages Of Streptococcus Mutans In Tooth Decay Bio Controlling Scialert Responsive Version

Pdf Comparative Evaluation Of Chlorhexidine And Sodium Fl Uoride Mouthwashes On Streptococcus Mutans

Unknown Identification Microbiology Resource Center Truckee Meadows Community College
Www Iasj Net Iasj Download 0f141fb3bcb0aab4



